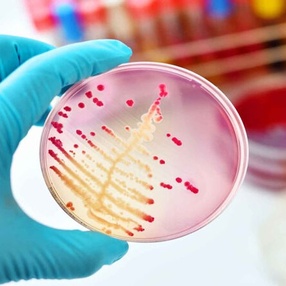
Менингококковая инфекция — опасное заболевание...

Профилактика клещевых инфекций
Иксодовые клещи могут быть переносчиками девяти возбудителей инфекционных заболеваний. На территории Беларуси регистрируются только два − клещевой энцефалит и Лайм боррелиоз. Иксодовые клещи распространены в лесах по всей территории нашей страны. Они влаголюбивы, предпочитают затененные и увлажненные лиственные и смешанные леса с густым травостоем и […]
Иерсиниоз: почему важно следить за гигиеной и питанием
Иерсиниоз — острая инфекционная болезнь человека и животных. Для заболевания типичны лихорадка, интоксикация, поражение желудочно-кишечного тракта, суставов, кожи, печени, склонность к волнообразному течению. Есть две клинические формы: кишечный иерсиниоз и псевдотуберкулез. Возбудители относятся к роду иерсиний (семейство энтеробактерий). Отличительная особенность — способность длительно […]
Лептоспироз — опасная инфекция, угрожающая здоровью человека
Лептоспироз — острая инфекционная болезнь, вызывается лептоспирами, передающимися человеку от животных. Характеризуется явлениями интоксикации с резко выраженными болями в мышцах, преимущественным поражением почек, печени, нервной и сосудистой систем, сопровождающаяся развитием геморрагического синдрома и нередко желтухи. Источниками лептоспирозной инфекции для людей являются дикие мелкие […]
31 мая – Всемирный день без табака
Ежегодно 31 мая отмечается Всемирный день без табака, установленный Всемирной организацией здравоохранения (ВОЗ) в 1987 году. Курение – это не просто вредная привычка, это глобальная эпидемия, уносящая ежегодно до 8 миллионов жизней. Миллион из них – жертвы пассивного курения. Идея этого дня заключается в повышении […]
Требования к работе детских дошкольных учреждений в летний период
21.05.2026 на базе государственного учреждения образования «Детский сад № 1 г.п.Вороново» проведено инструктивно-методическое совещание для руководителей учреждений, реализующих образовательную программу дошкольного образования. В данном совещании приняли участие представители отдела образования Вороновского райисполкома, Вороновской ЦРБ, МЧС, милиции и др. […]
Пляжный сезон — открыт!
С наступлением пляжного сезона специалистами Вороновского районного центра гигиены и эпидемиологии (далее — Вороновский районный ЦГЭ) с июня по август проводится оценка санитарного состояния и благоустройства зон отдыха, и еженедельный лабораторный контроль качества воды поверхностных водных объектов. В соответствии с решением Вороновского районного исполнительного комитета […]
Безопасный отдых у воды: интерактивная карта разрешённых мест Гродненской области
Государственное учреждение «Вороновский районный центр гигиены и эпидемиологии» в целях более широкого освещения информации о действующих ограничительных мероприятиях в ходе купального сезона 2026 года информирует население о доступе и использовании интерактивной карты разрешенных мест пользования поверхностными водными объектами для рекреации, спорта и туризма на территории Гродненской области, действующих в 2026 […]
Безопасность детей летом
«Лето – это маленькая жизнь» – так красиво и точно сказано в известной песне Олега Митяева. Однако эту «маленькую жизнь» необходимо правильно обустроить, наполнить важными, интересными, полезными для ребенка занятиями, а самое главное – создать безопасные условия пребывания детей в воспитательно-оздоровительных учреждениях. С […]
Организация питания во время весенних полевых работ
Специалистами Вороновского районного ЦГЭ в составе межведомственной группы проведены оценочные мероприятия организации питания работников задействованных в весенних полевых работах. Проведена оценка 8 субъектов хозяйствования, нарушения во всех субъектах. Типичные нарушения: не осуществлялся производственный контроль за организацией питания в полевых условиях: […]
Лямблиоз: понимание и преодоление паразитарной инфекции
Лямблии — простейшие микроорганизмы, паразитирующие в просвете тонкого кишечника человека. Вызываемое ими состояние — лямблиоз, не несет угрозы для жизни, но опасен последствиями и осложнениями, включающими стойкие нарушения работы внутренних органов и систем. Лямблиоз распространен повсеместно: инвазированность лямблиями взрослого населения составляет 3-5%, детей в организованных […]
Питание школьников
29.04.2026 на базе ГУО «Радунская средняя школа» для обучающихся 5-8 классов специалистом Вороновского районного ЦГЭ проведено заседание «круглого стола» в рамках информационной акции «Традиции здорового питания школьников» на тему: «Правильное и рациональное питание – залог здоровья». Питание школьников – это очень сложный вопрос. […]
Клуб здоровья для людей «креативного» возраста
Государственным учреждением «Вороновский центр гигиены и эпидемиологии» на основании положения организована работа клуба здоровья для людей «креативного» возраста «Энергия жизни!». 29.04.2025 на базе филиала «Радунский центр национальных культур» помощником врача-гигиениста санитарно-эпидемиологического отдела Метелица И.И. обсуждалась тема «Влияние стресса на организм человека и как с ним […]
Результаты месячника безопасности труда во время весенних полевых работ
Государственное учреждение «Вороновский районный ЦГЭ» информирует, что в рамках месячника безопасности труда во время весенних полевых работ специалистом Вороновского районного ЦГЭ в составе межведомственной группы проведена оценка 11 ремонтно-механических мастерских, 11 зерноскладов. Нарушения условий труда выявлено на 22 объектах (100%). При проведении надзорных […]
Европейская неделя иммунизации
Европейская неделя иммунизации (ЕНИ) — это ежегодная инициатива ВОЗ, призванная повысить осведомленность о важности вакцинации. В Беларуси и других странах Европы она традиционно проходит весной, напоминая о необходимости защиты от опасных инфекций. Вакцинация предотвращает от 2 до 3 миллионов смертей ежегодно, являясь одним из самых […]
Сохранение памяти о коллегах — это то, что делает наш коллектив сильнее
Посещение кладбища председателем первичной профсоюзной организации и молодыми специалистами Вороновского районного ЦГЭ в преддверии Радуницы (которая в 2026 году выпадает на 21 апреля) стало важным этапом весеннего марафона по благоустройству. В белорусской традиции Радуница — день поминовения усопших. Проведение уборки именно в эти дни подчеркивает […]
17 апреля — Всемирный день больных гемофилией
Гемофилия — это наследственное нарушение свертываемости крови, при котором в организме отсутствует или недостаточно функционирует один из факторов свертывания — белковые элементы, необходимые для остановки кровотечений. Существует несколько типов этого заболевания, наиболее распространёнными из которых являются: Гемофилия типа A — недостаток фактора VIII. […]
16 апреля — Международный день голоса
Голос — это наше «личное лицо», оно помогает установить контакт, выразить чувства, донести мысли и идеи. Особенно важен голос для людей профессионально связанной с публичными выступлениями, педагогов, артистов, дикторов, педагогов, представителей сферы коммуникаций. Однако многие не задумываются о необходимости беречь свой голос. Повышенная нагрузка, неправильная техника […]
Сезон кишечных инфекций
С наступлением теплых дней возрастает опасность заражения острыми кишечными инфекциями (далее — ОКИ). кишечные инфекции – это многочисленная группа острых инфекционных заболеваний, вызываемых различными микроорганизмами, простейшими, бактериями, вирусами с преимущественным поражением желудочно-кишечного тракта. ОКИ в организм человека попадают с пищей, водой, у […]
Минимизация последствий аварии на ЧАЭС
Радиационная безопасность – неотъемлемое условие санитарно-эпидемиологического благополучия. На сегодняшний день наибольшую опасность представляет внутреннее облучение, которому организм человека подвергается в результате употребления в пищу загрязненных радионуклидами продуктов питания. Продукты питания могут содержать отдельные радионуклиды (цезий-137, стронций-90), а также различного рода их смеси. Накопление радионуклидов в растительных и […]
7 апреля — Всемирный день здоровья
Республика Беларусь является участницей Комиссии по правам человека Содружества Независимых Государств и в текущем году председательствует в ней. В соответствии с Планом работы Комиссии на 2026 год, объявленным решением Совета глав государств СНГ Годом охраны здоровья, предусмотрена Межгосударственная акция «Неделя здоровья и прав человека в Содружестве Независимых Государств». В […]
Чисто не там, где убирают, а там, где не мусорят
Традиционно с наступлением теплых дней жители не только частных домовладений но и многоэтажных домов берутся за лопаты и грабли, чтобы навести порядок на придомовой территории. Снег быстро растаял, и весь мусор оказался на поверхности: пластиковые бутылки, упаковки от продуктов питания, целлофановые пакеты, окурки сигарет. Также после зимы имеют неприглядный вид бордюры, […]
Сезон кишечных инфекций
С наступлением теплых дней возрастает опасность заражения острыми кишечными инфекциями (далее — ОКИ). Острые кишечные инфекции – это многочисленная группа острых инфекционных заболеваний, вызываемых различными микроорганизмами, простейшими, бактериями, вирусами с преимущественным поражением желудочно-кишечного тракта. Возбудители ОКИ в организм человека попадают с пищей, водой, […]
Обследование сельскохозяйственных организаций совместно с профсоюзами агропромышленного комплекса
Специалистами Вороновского районного ЦГЭ совместно с профсоюзами агропромышленного комплекса проведена оценка соблюдения требований законодательства, в том числе в области санитарно-эпидемиологического благополучия населения, условий труда работников, занятых при проведении массовых полевых работ, уделяя особое внимание условиям труда женщин. Оценка проведена в 2 субъектах хозяйствования (7 объектах): КСУП «Дотишки», КСУП «Мисевичи». В ходе обследования […]
Наркомания: причины, последствия и меры профилактики
Наркомания – это пристрастие к употреблению наркотиков, болезненное влечение, которое приводит к тяжелым нарушениям, в первую очередь, психических и физических функций организма. Ни для кого не секрет, что наркотики -яд. Независимо от принимаемого количества, они наносят непоправимый ущерб нашему здоровью. Наркотики, благодаря своему действию на психику, чаще […]
Для сведения покупателей БАДов
Государственное учреждение «Вороновский районный центр гигиены и эпидемиологиии» при проведении контроля реализации биологически активных добавок через интернет выявлены 3 основных нарушений требований законодательства, с которыми может столкнуться потребитель при покупке биологически активных добавок через интернет: 1. Превышение безопасных дозировок: некоторые добавки содержат дозы витаминов и других веществ, которые значительно превышают допустимые […]
20 марта – День профилактики заболеваний полости рта
Оральное здоровье – это не просто красота улыбки: это важная составляющая общего благополучия каждого человека. Заболевания ротовой полости могут привести не только к дискомфорту и боли, но и стать причиной серьезных общих заболеваний. Поэтому профилактика заболеваний полости рта играет ключевую роль в поддержании здоровья всего организма. Основы профилактики […]
Правила поведения во время и после паводка: профилактика острых кишечных инфекций
Паводки — это природные явления, которые могут привести к затоплению территорий, повреждению инфраструктуры и повышению рисков для здоровья населения. Одним из серьезных последствий паводка является рост заболеваемости острыми кишечными инфекциями. Чтобы защитить себя и своих близких, важно соблюдать определённые правила поведения и профилактики. Риски во время и […]
Вороново — здоровый поселок: формирование ЗОЖ среди молодежи
16.03.2026 в рамках профилактического проекта «Вороново — здоровый поселок» специалистами Вороновского районного ЦГЭ проведена информационно-образовательная акция «Молодежный старт к здоровью» (#МолодежьPROЗОЖ) в УО «Вороновский государственный колледж». Целью акции является формирование устойчивой внутренней мотивации к здоровому образу жизни как естественной, модной и доступной нормы через позитивные, интерактивные и референтные для молодежи […]
Что мы знаем про березовый сок
Березовый сок — это прозрачная жидкость, которую получают из надломленных ветвей или специальных зарубок в стволе березы. Вопреки названию, к истинному соку, например, как у цитрусовых, сок березы отношения не имеет — ни по вкусу, ни по составу. Еще осенью корни деревьев накапливают различные полезные вещества, необходимые дереву весной. При первой […]
Профилактика туберкулеза: важные меры для защиты здоровья
Туберкулез — опасное инфекционное заболевание вызываемое палочкой Коха, которое чаще всего поражает легкие. Главным источником инфекции являются люди с болезнью в открытой форме. Пути передачи возбудителя: воздушно-капельный – при чихании и кашле бактерии оказываются в воздухе, который вдыхают здоровые люди. Кроме того, микроорганизмы […]
Вороновский район готовится к месячнику по благоустройству: призыв к активному участию
Государственное учреждение «Вороновский районный центр гигиены и эпидемиологии» (далее – Вороновский районный ЦГЭ) информирует, что после схода зимнего снежного покрова наиболее остро обострились вопросы поддержания санитарного состояния территорий населённых пунктов и объектов, закрепленных за организациями, в надлежащем состоянии. Согласно Решения Вороновского районного исполнительного комитета от 12 марта 2026 […]
И снова про грибы…
В связи с началом грибного сезона Вороновский районный центр гигиены и эпидемиологии разъясняет основные правила профилактики отравлений «дарами леса». Грибной сезон весной открывают сморчки и строчки. Эти грибы похожи, и грибники их часто путают. Строчки и сморчки относятся к разряду условно съедобных грибов. Они ядовиты для тех, кто […]
Профилактическая беседа по вопросам пожарной безопасности и выхода на лед в Вороновском районе
В рамках проведения профилактических мероприятий 11.03.2026 с коллективом Вороновского районного ЦГЭ инспектором сектора надзора и профилактики Вороновского РОЧС Даниилом Юрьевичем Алешкиным была организована беседа по вопросам содержания автономных пожарных извещателей (АПИ), правильной техники паления сорной, сухой растительности, а также о безопасности выхода на лед в весенний период. […]
Профилактика отравлений пестицидами
С наступлением весны и посевной кампании в сельскохозяйственных организациях начинается сезон протравливания семян. Эти работы требуют соблюдения определенных мер безопасности. Ежегодно перед посевной компанией сотрудниками Вороновского районного ЦГЭ проводится разъяснительная работа по мерам безопасности при работе пестицидами (средствами защиты растений), агрохимикатами и минеральными удобрениями. […]
#МолодежьPROЗОЖ
В рамках информационно-образовательной акции «Молодежный старт к здоровью» (#МолодежьPROЗОЖ) мы хотим обратить внимание не только на формирование устойчивой внутренней мотивации к здоровому образу жизни, на профилактику вредных привычек, но и на ключевые компоненты цифровой гигиены для здорового образа жизни. Что такое цифровая гигиена? Цифровая гигиена представляет собой совокупность правил и методов, нацеленных […]
12 марта — Всемирный день почки
Всемирный день почки отмечается ежегодно для повышения осведомленности о важности этого органа и профилактики почечных заболеваний. Основная цель — раннее выявление болезней почек, так как 8-10% населения мира страдают патологиями, часто протекающими бессимптомно. Почки – один из главнейших органов нашего организма. Через почки проходит вся наша кровь, с […]
3 марта — Международный день охраны здоровья уха и слуха
Рост проблем, связанных с потерей слуха у населения в глобальном масштабе, побудил Всемирную организацию здравоохранения учредить специальный день, посвященный охране здоровья уха и слуха. Ежегодно 3 марта отмечается Международный день охраны здоровья уха и слуха (International Day for Ear and Hearing). Выбранная дата праздника имеет символическое значение. Числа, которыми […]
Ответственный подход к профилактике половых инфекций
Инфекции, передающиеся половым путем (далее – ИППП), относят к числу социально значимых. Они включают более 20 нозологических форм: сифилис, гонорея, хламидиоз, микоплазмоз, трихомониаз, папиллома, вирусная инфекция, генитальный герпес и др. Нередко наблюдается одномоментное заражение несколькими ИППП. Наличие у человека ИППП значительно повышает риск заражения самой грозной инфекцией — ВИЧ. Возбудителями ИППП являются патогенные […]
Важность правильного питания в жизни школьника
Наше здоровье – самое ценное, что у нас есть. Обычно мамы ответственно подходят к питанию маленьких детей, старясь выполнять все рекомендации врачей-педиатров. А когда ребенок идет в школу? Школа – это большая нагрузка для детского организма, и физическая, и психологическая, и интеллектуальная. И школьнику, как никогда, необходимо питаться таким […]
Что необходимо знать о БАДах
Здоровье человека, по определению ВОЗ, является главным критерием качества его жизни. В настоящее время большое внимание населением уделяется использованию биологически активных добавок к пище, так называемых БАДов, для его укрепления. Рынок БАД в нашей республике развивается и набирает обороты с устойчивой тенденцией к росту как в денежном, так […]
Профилактика пожаров
С наступлением холодной погоды значительно увеличивается количество огненных происшествий, возникающих из-за нарушения правил пожарной безопасности при эксплуатации печного отопления. И виной тому – человеческая беспечность. Наличие в доме или квартире автономных пожарных извещателей существенно повышает возможность раньше узнать о пожаре, принять соответствующие меры и избежать печальных последствий. […]
Правила безопасности катания на тюбингах
Катание на тюбингах (в народе называемых «ватрушками» или «бубликами») – это отдых, который одинаково подходит взрослым и детям, но, к сожалению, это еще и один из самых травмоопасных видов отдыха. В отличие от санок «ватрушки» способны развивать большую скорость и даже закручиваться вокруг своей оси во время спуска. При этом они […]
Зимняя витаминотерапия: ключ к крепкому иммунитету
Зима — это период, когда наш организм нуждается в особой поддержке. Короткий световой день, холодная погода и ограниченное количество свежих овощей и фруктов в рационе могут привести к нехватке жизненно важных микроэлементов. Перечислить каких витаминов не хватает в осенне-зимний период невозможно, так как это очень индивидуально и зависит от состояния организма […]
Что необходимо знать о кори
В последние годы на территории нашей страны диагноз корь стал звучать гораздо чаще. И несмотря на то, что ситуация по заболеваемости стабильная и контролируемая, бдительности как медикам, так и населению терять не стоит. Корь — это острое вирусное заболевание, которое передается через выделения из носа, рта и горла […]
Здоровый образ жизни и здоровье детей
22.01.2026 в ГУО «Детский сад № 4 г.п.Вороново» проведено родительское собрание на тему «Здоровый я – здоровая страна», помощником врача-гигиениста Вороновского районного ЦГЭ была освещена тема: «Здоровый образ жизни и здоровье детей». «Здоровье дороже золота», — сказал английский поэт и драматург Уильям Шекспир. Наше здоровье – самое ценное, что у […]
Профилактика гриппа и ОРИ
Острые респираторные инфекции (ОРИ) и грипп продолжают оставаться актуальными в зимний сезон. Острые респираторные инфекции- группа заболеваний, которые вызываются множеством возбудителей (вирусы гриппа, парагриппа, аденовирусы, метапнемовирус и другие). Все ОРИ характеризуются острым поражением дыхательной системы человека, симптомы ОРИ: першение или боль в горле, насморк или заложенность носа, осиплость голоса, кашель, повышение […]
Менингококковая инфекция — опасное заболевание…
Менингококковая инфекция — опасное заболевание с высокой вероятностью летального исхода. Возбудителем болезни является микроб менингококк, который может существовать в слизи носоглотки у абсолютно здоровых людей. Их называют бактерионосителями и ими чаще всего бывают лица молодого возраста, от 19 до 28 лет. Бактерия имеет плотную оболочку — капсулу. […]
Основные правила респираторного этикета
Респираторный этикет — это свод правил поведения (при кашле и чихании прикрывать рот сгибом локтя или платком, мыть руки, носить маску при болезни), которые помогают предотвратить распространение респираторных инфекций, защищая окружающих от вирусов, и проявляют уважение к другим людям. Основные правила респираторного этикета: 1. При кашле и […]
Физическая активность в зимний период: как сохранить бодрость и здоровье зимой
Зима — это не только время праздников и уютных вечеров у камина, но и период, когда многие из нас склонны к пассивности, снижению мотивации и ухудшению общего самочувствия. Однако физическая активность зимой играет важную роль для поддержания здоровья, энергии и хорошего настроения. Ниже рассмотрим, почему важно двигаться зимой и как сделать […]
Как уберечься от травм во время гололеда?
Зима прекрасная пора года, однако, с приходом снегопада, мороза и перепадов температуры люди травмируются. Чтобы себя обезопасить по возможности старайтесь не выходить из дома, особенно — в темное время суток. Это самая действенная защита от травм. Если все же приходится выйти, в первую очередь обратите внимание на обувь. Она должен […]
Обеспечение безопасных условий труда в зимний период: меры защиты при морозах
С наступлением холодного периода года, в частности мороза, актуальным вопросом является создание здоровых и безопасных условий труда работающих, проведение нанимателем мер защиты при работе на открытом воздухе и при несоответствии температуры гигиеническим нормативам на рабочих местах. Параметры микроклимата на рабочих местах должны соответствовать требованиям гигиенических нормативов «Микроклиматические […]
Первые морозы: что нужно знать об обморожении
Обморожение — повреждение кожи и тканей из-за холода. Основной механизм развития холодовой травмы кроется не столько в замерзании клеток, сколько в резком нарушении кровообращения из-за спазма сосудов. Всего выделяют 4 степени тяжести обморожения. Сразу понять, насколько серьезно обморожение, невозможно. Точная степень повреждения станет ясна только после согревания, а иногда даже через несколько дней. […]
Как правильно выбрать стеклоомывающую жидкость
С приходом зимы, мороза перед автовладельцами традиционно встает вопрос приобретения стеклоомывающей жидкости для транспортных средств. Чтобы защитить автомобиль от некачественной продукции, специалисты рекомендуют: — покупать жидкости только в установленных для торговли местах, поскольку продукция, продаваемая «с обочины», – в большинстве случаев контрафакт, содержащий метанол. — Внимательно изучайте маркировку: жидкость должна быть предназначена исключительно […]
О разъяснении требований законодательства в области санитарно-эпидемиологического благополучия населения, предъявляемых к содержанию территорий торговых объектов
Государственное учреждение «Вороновский районный центр гигиены и эпидемиологии» информирует, что на объектах торговли и общественного питания по-прежнему выявляются факты не содержания в чистоте территории. С целью предупреждения выявления указанных нарушений на Ваших объектах, разъясняем требования законодательства по содержанию территории торговых объектов. Пункт 17 […]
Профилактика гололедных травм
Гололед – это слой плотного льда, образовавшийся на поверхности земли, тротуарах, проезжей части улицы и на предметах (деревьях, проводах и т.д.) при намерзании переохлажденного дождя и мороси (тумана). Обычно гололед наблюдается при температуре воздуха от 0 0С до минус 3 0С. Корка намерзшего льда может достигать нескольких сантиметров. Если в прогнозе погоды дается […]
Что нужно знать о кори? Предотвратить заболевание — наш общий долг
Корь – высококонтагиозное и чрезвычайно заразное острое вирусное заболевание, передающееся воздушно-капельным путем. Источник инфекции – больной человек, который заразен в течении 10 дней от начала заболевания. Вирус кори поражает дыхательные пути, затем распространяется по всему организму. Корь обычно начинается с высокой температуры, появление насморка, боли в горле и коньюктивита, […]
Семинар, на тему «Основные требования Санитарных норм и правил «Санитарно-эпидемиологические требования к содержанию и эксплуатации агроэкоусадеб»
Специалистами Вороновского районного ЦГЭ в актовом зале Вороновского районного ЦГЭ проведен семинар, на тему «Основные требования Санитарных норм и правил «Санитарно-эпидемиологические требования к содержанию и эксплуатации агроэкоусадеб», утвержденных постановлением Министерства здравоохранения Республики Беларусь от 18.12.2022 № 116, Специфических санитарно-эпидемиологических требований к содержанию и эксплуатации общежитий и иных мест проживания, утвержденных постановлением Совета […]
О проведении обязательных медицинских осмотров работающих
Порядок проведения обязательных медицинских осмотров работающих, занятых на работах с вредными и (или) опасными условиями труда и (или) на работах, где в соответствии с законодательством есть необходимость в профессиональном отборе, а также внеочередных медицинских осмотров работающих определена Инструкцией «О порядке проведения обязательных и внеочередных медицинских осмотров работающих», утвержденной постановлением Министерства здравоохранения Республики […]
15 декабря — День профилактики производственного травматизма
Производственный травматизм — это совокупность травм, полученных работниками на рабочем месте или во время выполнения трудовых обязанностей. Травмы могут быть легкими, тяжелыми и даже смертельными. К ним относятся: — переломы, ушибы, порезы; — ожоги, обморожения; — повреждения от электрического тока; — травмы, вызванные падением с высоты или падением предметов; Причины производственного травматизма […]
Новогодний переполох
Новый год – время волшебства и исполнения заветных желаний. Время подготовки к празднику традиционно приносит заботы о приобретении подарков близким, коллегам и партнёрам.. Выбор новогодних подарков — это сочетание внимания, вкуса и понимания эмоций. Лучший подарок — тот, который продолжает радовать человека и после праздников. Осознанный подход и заранее […]
Загляните за границы привычных покупок: почему важно внимательно смотреть не только на свежесть продуктов, но и на качество других товаров
Загляните за границы привычных покупок: почему важно внимательно смотреть не только на свежесть продуктов, но и на качество других товаров. Когда мы идем за покупками, часто сосредотачиваемся на свежих продуктах питания и забываем обратить внимание на другие важные вещи — бытовую химию, косметику, товары для дома. А ведь именно […]
Гигиена, профилактика и внимательное отношение к окружающей среде — важные меры для защиты от туляремии
Туляремия — это острое инфекционное заболевание, которое вызывается бактерией Francisella tularensis и поражает лимфатические узлы, кожу, слизистые оболочки, легкие и желудочно-кишечный тракт. Болезнь характеризуется лихорадкой и интоксикацией. В настоящее время на территории Республики Беларусь зарегистрировано 97 природных очагов туляремии, из них 41,2% находятся в Минской области, 38,1% – […]
16 ноября – Всемирный день некурения. Профилактика онкологических заболеваний
Всемирный день некурения посвящен, прежде всего, профилактике онкологических заболеваний, так как по данным Международного союза по борьбе с раком (UICC) сегодня 30% всех случаев смерти от рака связаны с курением. Употребление табака является самой значительной предотвратимой причиной смерти, и в настоящее время, по данным ВОЗ, приводит к смерти каждого десятого взрослого человека в […]
«Здоровье на работе – победим диабет вместе»
В рамках проекта «Вороново – здоровый поселок» специалистами Вороновского районного ЦГЭ совместно с медицинскими работниками УЗ «Вороновская ЦРБ» 14.11.2025 приняли участие в республиканской акции «Здоровье на работе – победим диабет вместе» на базе ГУО «Вороновская средняя школа». Все желающие смогли получить индивидуальное консультирование, информационно-образовательные материалы (буклеты, листовки, памятки), узнать […]
14 ноября — Всемирный день борьбы с диабетом
Этот день служит важным напоминанием всему прогрессивному человечеству о том, что распространённость заболевания неуклонно возрастает. Диабет – хроническое заболевание, которое возникает либо в случаях, когда поджелудочная железа не вырабатывает достаточное количество инсулина, либо когда организм не может эффективно использовать вырабатываемый инсулин. Инсулин – это гормон, регулирующий уровень глюкозы в […]
11-17 ноября – Всемирная неделя рационального использования антибиотиков
Рациональное использование антибиотиков: что это значит и почему это важно? Антибиотики — это лекарства, которые помогают бороться с бактериальными инфекциями. Они спасают жизни, но их неправильное использование может привести к серьезным проблемам. Антибиотики — это вещества, которые убивают или замедляют рост бактерий. Они не действуют на […]
Специалистами Вороновского районного ЦГЭ организовано информационно-образовательное мероприятие в рамках республиканской информационно-образовательной антиникотиновой акции
В рамках проекта «Вороново — здоровый поселок» специалистами Вороновского районного ЦГЭ в магазине «Евроопт» ООО «Евроторг» в рамках республиканской информационно-образовательной антиникотиновой акции организовано информационно-образовательное мероприятие, в ходе которого проведена проверка объема легких (способом надувания воздушных шариков), обмен сигареты на конфету, опрос по вопросам профилактики табакокурения, «Какой выбор Вы делаете?» (с отметкой стикером […]
29 октября — Всемирный день борьбы с псориазом
29 октября в международном календаре обозначен как Всемирный день борьбы с псориазом или Всемирный день псориаза. Эта дата в первую очередь затрагивает тех людей, которые страдают от этого заболевания, а также врачей-дерматологов, помогающих людям лечить его. Псориаз – это хроническое аутоиммунное заболевание кожи, характеризующееся быстрым развитием новых клеток эпидермиса […]
Онкология: факторы риска
Онкологическое заболевание (злокачественная опухоль) — это новообразование, обусловленное патологическим ростом клеток (обычно возникает из одной патологической клетки). Клетки утрачивают нормальный механизм контроля и приобретают способность непрерывно размножаться, вторгаться в близлежащие ткани, мигрировать в отдаленные участки организма и способствовать возникновению новых кровеносных сосудов, которые обеспечивают клетки питательными веществами. Опухолевые (злокачественные) клетки могут развиваться […]
21 октября – День отца
В Беларуси День отца отмечается 21 октября и учрежден Указом Президента №198 от 9 июня 2022 года. Этот праздник призван повысить значение роли отца в воспитании детей и укреплении традиционных семейных ценностей. Период с 14 по 21 октября, между Днем матери (14 октября) и Днем отца, назван Республиканской Неделей родительской любви. […]
16 октября — Международный день здорового питания
Международный день здорового питания отмечается 16 октября и является важным событием, посвященным вопросам питания и здоровья. Этот день призван повысить осведомленность о значении правильного питания для здоровья человека и устойчивого развития общества. Международный день здорового питания был учрежден в 2014 году и дата 16 октября была выбрана не случайно: в этот […]
О наведении порядка и благоустройстве на территории Вороновского районного ЦГЭ
Государственное учреждение «Вороновский районный центр гигиены и эпидемиологии» напоминает, что 2025 год объявлен Годом благоустройства. Но в первую очередь, мы начинаем с себя. Ежегодно, нашей организацией проводится текущий ремонт, поддержание в чистоте нашей территории. В 2025 году проведена более масштабная работа: замена отмостки административного здания, посадка новой клумбы с различными декоративными растениями […]
Поздравим маму вместе…
Мама — главное слово в судьбе. Кто-то из нас стал отмечать этот праздник несколько лет назад, кто-то уже может зваться мамой дважды, кто-то трижды, а кто-то и вовсе дал жизнь чьей-то маме и носит гордое звание бабушки. Благодаря Вам, матерям, и продолжается род человеческий. С теплыми словами поздравила коллектив главный врач Вороновского районного […]
14 октября — День матери
В середине осени – 14 октября – Беларусь отмечает День матери, начиная с 1996 года. Дата празднования приурочена к великому православному празднику – Покрову Пресвятой Богородицы. День матери в Беларуси – это праздник любви и заботы. Он посвящен самым важным женщинам в нашей жизни — нашим матерям. Этот день дает нам […]
В Вороново начали вакцинировать девочек от инфекции, вызванной вирусом папилломы человека
С января 2025 года в Национальный календарь профилактических прививок внесена вакцинация против инфекции, вызванной ВПЧ. В Вороновском районе можно пройти ее курс бивалентной вакциной «Цеколин». Бесплатно она проводится девочкам, которым в текущем году исполняется 11 лет. Курс вакцинации состоит из двух прививок интервалом шесть месяцев. Вирус папилломы человека (ВПЧ) инфицирует кожу и слизистые […]
Ревматоидный артрит: что это такое и как с ним жить?
Ревматоидный артрит (РА) — это не просто медицинский термин, который сложно произнести. Это реальное заболевание, которое затрагивает миллионы людей по всему миру. Разберёмся, что это за недуг, как он проявляется и что можно с ним сделать. Ревматоидный артрит — это хроническое воспалительное заболевание, которое в первую очередь поражает суставы. Представьте, что […]
Не заходи за черту, не сломай себе жизнь
В последнее время тема наркотиков стала на страницах прессы одной из самых популярных. И это не случайно, ведь статистика безжалостно свидетельствует о небывалом росте продажи и употребления наркотических средств. Сегодня наркомания поразила все страны мира, в том числе и нашу страну. Безусловно, одной из наиболее важных проблем, стоящих перед […]
Качество и безопасность питьевой воды в Вороновском районе
Вода — основа жизни на Земле. Ее достаточное количество, доступность, а так же качественные показатели напрямую влияют на все важнейшие процессы в природе и жизни человека. В современном мире сложно представить комфортную жизнь без качественной и безопасной питьевой воды. Специалистами государственного учреждения «Вороновский районный центр гигиены и эпидемиологии» осуществляется постоянный контроль […]
1 октября – Международный день пожилых людей
День пожилых людей в Беларуси – это добрый и светлый праздник, когда родители, бабушки и дедушки (свои и чужие) окружаются особым вниманием. Простая помощь и поддержка имеют особенное значение для пожилых людей. Всегда нужно помнить о текущих потребностях пожилых людей, оказывать им поддержку в соответствии с их социальным статусом, вызванным ограничением либо прекращением […]
«Неделя нулевого травматизма» с 22.09.2025 по 28.09.2025
25 сентября 2025 года в ГУ «Вороновский районный ЦГЭ» проведено отраслевое мероприятие «Неделя нулевого травматизма» на тему: «Укусы и иные телесные повреждения, нанесенные животными: взгляд на причину не локально, а комплексно». Рассмотрены вопросы об организации контроля за состоянием условий труда на рабочих местах, за правильностью применения работниками средств индивидуальной защиты. О безопасности при проведении […]
10 сентября — Всемирный день предотвращения самоубийств
Всемирный день предотвращения самоубийств отмечается 10 сентября каждого года. Этот день был установлен с целью повышения осведомленности о проблеме самоубийств и поддержки тех, кто находится в кризисной ситуации. Самоубийство является одной из основных причин смерти во всем мире, и важно говорить об этом открыто, чтобы снизить количество трагических случаев. […]
Всемирный день предотвращения самоубийств
Всемирный день предотвращения самоубийств отмечается 10 сентября каждого года. Этот день был установлен с целью повышения осведомленности о проблеме самоубийств и поддержки тех, кто находится в кризисной ситуации. Самоубийство является одной из основных причин смерти во всем мире, и важно говорить об этом открыто, чтобы снизить количество трагических случаев. […]
Правильное питание – залог здоровья. В Вороновском районном ЦГЭ проведен обучающий семинар для работников объектов питания учреждений образования
Наше здоровье – самое ценное, что у нас есть. Одним из главных условий нормального развития школьника является правильное питание. В детском организме происходят чрезвычайно важные внутренние изменения (формируется нервная, эндокринная, лимфатическая, дыхательная, иммунная и другие системы). Большую часть времени школьники проводят в школе, выполняя тяжёлый труд – получение и усвоение знаний по […]
Осторожно – бешенство!
За 2024 год за оказанием помощи по поводу покусов животными в УЗ «Вороновская ЦРБ» обратилось 25 человек. С начала 2025 года по текущий период обратилось 25 человек. Пострадавшим назначены прививки против бешенства. Бешенство – смертельное заболевание, которое передается другим животным и людям при контакте со слюной больного животного. […]
Как выбрать учебное пособие?
Последний месяц лета. Родители обеспокоены покупкой учебных пособий к началу учебного года для своего ребенка. Что выбрать? На что надо обратить внимание? Торговля предлагает очень большой ассортимент печатной продукции для детей разного возраста. Учебники и учебные пособия должны соответствовать ряду требований, включая соответствие образовательным стандартам, методическую проработку содержания, удобство […]
Как выбрать школьный рюкзак для младших школьников?
Скоро в школу, и родителям необходимо выбрать самую необходимую вещь для ребенка – это рюкзак. Наша торговля предлагает широкий ассортимент рюкзаков на любой вкус и цвет. Как выбрать правильный рюкзак для ребенка? При выборе школьного рюкзака для младших школьников важно учесть несколько ключевых моментов. […]
Голосуй за трезвость!
Когда человек начинает пить спиртное, он редко задумывается о последствиях. Время идет, и на определенной стадии злоупотребление алкоголем становится постоянной частью его жизни. Первая стадия зависимости может казаться безобидной: человек употребляет алкоголь в компании близких, находясь в хорошем настроении, и дело идет о небольших дозах. Однако, […]
Специалистами Вороновского районного ЦГЭ проведен круглый стол в ГУО «Оздоровительный лагерь «Ромашка»
Специалистами Вороновского районного ЦГЭ проведен круглый стол в ГУО «Оздоровительный лагерь «Ромашка» в рамках проведения областной акции «Каникулы в ритме ЗОЖ» на тему «Здоровый образ жизни». Целью данного мероприятия является популяризация здорового образа жизни среди отдыхающей молодежи, формирование активной жизненной позиции и ценностного отношения к своему здоровью. […]
13 августа — Всемирный день донорства органов
Всемирный день донорства органов отмечается ежегодно 13 августа. Донорство органов — это процесс, при котором человек позволяет изъять собственный орган или ткань и пересадить его другому человеку. Органы и ткани, которые трансплантируются относительно часто, включают сердце, легкие, почки, печень, поджелудочную железу, кишечник, роговицу глаз и кожу. Одна из первых успешных трансплантаций […]
Порядок — не рекомендация, а требование. В Вороновском райисполкоме прошло заседание штаба по наведению порядка на земле и благоустройству населенных пунктов
Под руководством председателя Вороновского райисполкома Василия Шлыка прошло очередное заседание районного штаба по наведению порядка на земле и благоустройству населенных пунктов. В мероприятии приняли участие председатель районного Совета депутатов Елена Ганевич, заместители председателя райисполкома, а также представители различных отделов и служб, руководители местных организаций, предприятий и учреждений. — Вопросы наведения порядка остро […]
1 августа — Всемирный день борьбы с раком легкого
Каждый год 1 августа мир отмечает Всемирный день борьбы с раком легкого. Цель этого Дня — повышение уровня осведомленности населения о данном заболевании, о его влиянии на здоровье человека и общества, факторах риска, способах его выявления, профилактики и лечения. Этот день призван привлечь внимание к одной из самых распространенных и опасных форм […]
14 июня — всемирный день донора крови
Безопасная кровь нужна повсеместно. Она жизненно необходима как для лечения, так и для экстренной медицинской помощи. Она используется для продления и улучшения жизни пациентов, страдающих смертельно опасными заболеваниями, и для проведения сложных медицинских и хирургических процедур. Кроме того, кровь применяется для лечения раненых в чрезвычайных ситуациях любого рода (стихийные бедствия, […]
Памятка для выезжающих за рубеж
Подготовка к командировке Вы запланировали командировку, определили дату отъезда и срок пребывания в стране? Наши советы помогут сделать поездку безопасной и комфортной. Заранее до отъезда обратитесь к врачу в поликлинике по месту жительства для получения медицинских рекомендаций по пребыванию […]
СДЕЛАЙ ПРАВИЛЬНЫЙ ВЫБОР
31 мая во всех странах мира, в том числе и в Беларуси, проводят Всемирный день без табака. Одна из распространенных вредных привычек у человека – это зависимость от курения. Важно рассказать о вреде курения и подсказать, как сделать первый шаг к ведению здорового образа жизни. […]
О проведении мероприятия профилактической направленности среди сельскохозяйственных организаций
28.05.2025 года помощником врача-гигиениста санитарно-эпидемиологического отдела Вороновского районного ЦГЭ Волынец Наталией Эдуардовной в составе межведомственной рабочей группы проведены мероприятия профилактической направленности среди сельскохозяйственных организаций, по вопросам соблюдения законодательства в области санитарно-эпидемиологического благополучия населения при проведении сельскохозяйственных работ, в том числе организации питания работников во время полевых работ. Оценочные мероприятия проведены […]
15 мая — Международный День семьи
Семья – одна из главных жизненных опор каждого человека. Для всех нас именно семья является важнейшим источником счастья и любви. Теплые отношения между близкими людьми, взаимопонимание, поддержка друг друга, радость общения наполняют положительными эмоциями и делают более гармоничной нашу жизнь, дают нам силы преодолеть все трудности. Это вечные ценности, которые […]
5 мая — Всемирный день гигиены рук
Всемирная организация здравоохранения (ВОЗ) провозгласила 5 мая Всемирным днем гигиены рук. Дата 5.5. символизирует по 5 пальцев на каждой из рук человека. Этот день призван напомнить людям о влиянии мытья рук на здоровье. Соблюдение требований к гигиене рук – наиболее простая и доступная, но очень эффективная мера защиты от инфекционных […]
1 мая – Международный «Астма-день»
Ежегодно в первый вторник мая в мире отмечается Международный «Астма-день» (World Asthma Day). Международный астма-день был организован, чтобы привлечь внимание общества к проблеме бронхиальной астмы, повысить осведомленность населения о заболевании, его диагностике и лечении. Астма в переводе с греческого – «тяжелое дыхание». Автором этого термина считают Гиппократа, а в его трудах в […]
Здоровый сон. Что важно знать?
25.04.2025 в государственном учреждении «Вороновский районный центр гигиены и эпидемиологии» в рамках марафона здоровья «Вперед здоровый образ жизни, все болезни – назад!» проведено занятие для людей «креативного» возраста на тему «Здоровый сон: что важно знать?». Сон – это физиологическая потребность человека, точно такая же, как голод или […]
Благоустройство садоводческих товариществ и гаражных кооперативов: шаги к порядку и комфорту
Поддержание порядка и благоустройства на территориях садоводческих товариществ и гаражных кооперативов — неотъемлемая часть создания комфортных, безопасных и экологичных условий для жизни и деятельности их участников. От уровня ухода зависит не только внешний вид территории, но и её экологическая ситуация, безопасность и настроение жителей. Почему содержание территорий так важно? […]
Как защитить свой двор и создать безопасное пространство
2025 год в Беларуси объявлен Годом благоустройства – время превратить придомовые территории в уютные и безопасные зоны. Особое внимание стоит уделить защите от клещей: по наблюдениям эпидемиологов, укусы всё чаще фиксируются в частных дворах. Как минимизировать риски? Почему клещи атакуют дома? […]
17 апреля — Всемирный день гемофилии. Что важно знать…
Гемофилия является редким, но серьезным наследственным заболеванием, связанным с нарушением функции свертывания крови, что приводит к неконтролируемым и часто спонтанным кровотечениям и кровоизлияниям в различные органы и ткани. При гемофилии организм человека не может естественным способом остановить кровотечение, возникшее из-за повреждения кровеносного сосуда в результате травмы, хирургического вмешательства или стресса. Интенсивность […]
Действительно ли смузи полезны для организма?
Смузи – это мягкий, однородный густой коктейль из свежих или свежезамороженных ягод, фруктов, овощей и других продуктов, перебитых до пюреобразного состояния. Смузи насыщает организм витаминами, макро- и микроэлементами, клетчаткой, необходимыми для здоровой работы организма. И поэтому он чрезвычайно полезен. Особенно востребован напиток летом, когда овощи, фрукты и ягоды доступны. Однако в […]
Бешенство – вылечить нельзя, но предупредить можно!
Бешенство издавна считается самым страшным и смертельным заболеванием не только для животного, но и для человека. Бешенство – инфекционное заболевание, вирусной природы, которое передается от животного к животному и от животного к человеку при тесном контакте со слюной – укусах, оцарапывании, а также ослюнении поврежденной кожи и […]
Что важно знать о шоколаде?
Шоколад — сладкое лакомство, которое любят дети и взрослые, которое уместно дарить на любой праздник, которое добавляем в напитки…. Но в последние года шоколад стал менее вкусным, т.к. на рынке появляется все больше подделок. Как же выбрать настоящий шоколад высокого качества? Шоколад готовится из какао-бобов. Из этих […]
Как одевать на улицу ребенка?
Ежедневные прогулки на свежем воздухе – обязательное условие для полноценного развития ребенка уже с самого момента его рождения. В разное время года любую маму волнует вопрос как правильно одевать ребенка на прогулку? Давайте разберемся с этим вопросом. В детских дошкольных учреждениях в группах воспитателями вывешивается таблица с указанием температуры наружного […]
Каникулы в ритме ЗОЖ
Помощником врача-гигиениста Вороновского районного ЦГЭ Виолеттой Огар на базе ГУО «Беняконская средняя школа» проведен «круглый стол» в рамках проведения областной акции «Каникулы в ритме ЗОЖ» на тему «Здоровый образ жизни». Целью данного мероприятия является популяризация здорового образа жизни среди учащейся молодежи, формирование активной жизненной позиции и ценностного отношения к […]
24 марта – всемирный день борьбы с туберкулезом
Туберкулез – хроническое инфекционное заболевание, при котором поражаются разные органы (кожа, почки, кишечник, глаза, костно-суставная система и др.), но чаще всего легкие, продолжает оставаться достаточно распространенным заболеванием. Заразиться туберкулезом может каждый, но наиболее высокий риск имеют люди, находящиеся в тесном контакте с больным активной формой туберкулеза. Источниками туберкулезной инфекции являются больные […]
20 марта – всемирный день полости рта
Всемирный день здоровья полости рта — это международный день, провозглашающий важность здоровья полости рта для людей всех возрастов во всех странах мира. С каждым годом популярность мероприятия в общемировом масштабе неуклонно возрастает. Забота о полости рта является одним из основных компонентов общей профилактики и заботе об организме. Говоря о красоте и здоровье зубов, […]
Бешенство – вылечить нельзя, но предупредить можно!
Бешенство издавна считается самым страшным и смертельным заболеванием не только для животного, но и для человека. Бешенство – инфекционное заболевание, вирусной природы, которое передается от животного к животному и от животного к человеку при тесном контакте со слюной – укусах, оцарапывании, а также ослюнении поврежденной кожи и слизистых оболочек. Наиболее опасные локализации повреждений, нанесенных животными […]
В Вороново дан старт марафону «100 дней здоровья»
В Вороновском райисполкоме обсудили ход реализации проекта «Вороново — здоровый поселок» и дали старт марафону «100 дней здоровья». — В Беларуси, как и других странах, неинфекционная заболеваемость остается основной причиной высокой смертности населения, экономических потерь в связи с возникающей нетрудоспособностью и затратами на медобслуживание. Поэтому здоровье населения — это […]
Профилактика клещевых инфекций
С приходом весны и тепла на нас обрушиваются «сезонные» напасти, грозящие здоровью. Одна из них — появление иксодовых клещей, возможных переносчиков инфекционных заболеваний. В Беларуси регистрируются две наиболее опасные инфекции, связанные с иксодовыми клещами — клещевой энцефалит и болезнь Лайма (Лайм-Боррелиоз). Проблему укусов клещей не стоит недооценивать, как впрочем, […]
«Дом без насилия»
В Вороновском районе с 10 по 16 марта 2025 года проводится республиканская профилактическая акция «Дом без насилия». Цель мероприятия — вовлечь широкие слои населения в оказании и содействия государственным органам в решении проблем насилия в семье. СЕМЬЯ – одна из величайших ценностей, созданных человечеством за всю […]
Чистота начинается с тебя!
Важные составляющие привлекательного поселка, деревни, в целом района, магазинов, административных объектов, частных подворий – это не только выкрашенные фасады и вымытые окна, но и чистота прилегающей территории. Однако чтобы было чисто и красиво там, где мы живём, этого явно недостаточно, ведь порядок нужно и должно поддерживать постоянно. Как говорится, […]
Берегите слух – сейчас и всегда!
3 марта – международный день слуха На сегодняшний день потеря слуха считается самой распространенной сенсорной формой инвалидности в мире. Миллионы людей во всем мире живут с инвалидизирующей потерей слуха. Основными причинами глухоты и тугоухости (неполной потери слуха) называют генетические нарушения, хронические инфекции уха, ряд заболеваний: краснуха, корь, свинка, менингит, […]
Меры безопасности при работе пестицидами (средствами защиты растений), агрохимикатами и минеральными удобрениями
Начинается сезон массовых полевых работ, в ходе которого не возможно обойтись без применения ядохимикатов. Особую опасность для населения представляют пестициды — химические вещества, бактериологические препараты и продукты микробиологического синтеза, используемые и сельском хозяйстве для борьбы с вредителями и болезнями культурных растений, сорной растительностью, вредителями зерна и пищевых продуктов. Они, […]
Берегите слух – сейчас и всегда!
На сегодняшний день потеря слуха считается самой распространенной сенсорной формой инвалидности в мире. Миллионы людей во всем мире живут с инвалидизирующей потерей слуха. Основными причинами глухоты и тугоухости (неполной потери слуха) называют генетические нарушения, хронические инфекции уха, ряд заболеваний: краснуха, корь, свинка, менингит, — а также воздействие некоторых лекарственных […]
Сказать «нет» наркотикам
1 марта – Международный день борьбы с наркоманией Наркомания – это тяжелое заболевание, которое начинается со случайного (или под давлением) приема наркотиков, с последующим формированием вредной привычки постоянного употребления и в дальнейшем непреодолимого влечения к наркотикам. «С одного раза ничего не будет, да и остановиться всегда успею – была бы […]
Голосуй за Трезвость!
Некоторые считают, что периодическое употребление алкоголя небольшими дозами не приведет к алкогольной зависимости. Многие, особенно совершеннолетние люди, понимают, что алкоголь – это в принципе плохо, и что он может привести к алкоголизму, но все-равно употребляют спиртное. Обычно это пиво и другие слабоалкогольные напитки, с помощью которых можно поднять настроение, побеседовать в приятной […]
Сладкий яд. Чем опасен сахар
Сахар относится к одним из самых популярных продуктов питания. Его чаще используют в качестве добавки в различные блюда, а не как самостоятельный продукт. Люди употребляют его почти в каждом приеме пищи, не считая намеренных отказов. Меж тем, Всемирная организация здравоохранения рекомендует ограничить суточное потребление сахара до 5% от всей совокупности потребляемых калорий. Это составляет […]
Освещенность – важный фактор для здоровья населения
Ежегодно специалистами Вороновского районного центра гигиены и эпидемиологии проводится надзор за условиями труда работающих предприятий и организаций, в том числе за проведением производственного лабораторного контроля по разным факторам производственной среды: шуму, освещенности, вибрации, микроклимату и другое. В 2024 году среди сельскохозяйственных и промышленных предприятий чаще всего нестандартные результаты выявлялись по недостаточной освещенности на […]
Месячник безопасности труда в отрасли животноводства проводится в феврале 2025 года
Государственное учреждение «Вороновский районный центр гигиены и эпидемиологии» информирует, что в феврале 2025 года проводится месячник безопасности труда в отрасли животноводства. 10.02.2025 года помощником врача-гигиениста Вороновского районного ЦГЭ проведена оценка соблюдения требований законодательства в области санитарно-эпидемиологического благополучия населения условий труда работников в отрасли животноводства в КСУП «Гирки», проведено обследование […]
Гельминтоз или болезнь грязных рук
За день руки человека контактируют с десятками и сотнями самых разных поверхностей. Болезнетворные бактерии, вирусы, яйца паразитов скапливаются на коже рук, а затем могут попасть в организм человека и вызвать различные заболевания. Какие болезни передаются через грязные руки чаще? Острые кишечные инфекции — холера, дизентерия, брюшной […]
Гепатиты бывают разные
Вирусные гепатиты — группа инфекционных заболеваний, характеризующихся преимущественно поражением печени. Они могут проявляться различно, но среди основных симптомов выделяют желтуху и боли в правом подреберье. В настоящее время наиболее распространенны гепатиты B и C. Гепатит А (или болезнь Боткина). Передается фекально-оральным путем, то есть через грязные руки. Вылечивается почти […]
Корь. Что важно знать
Корь – одна из самых заразных вирусных инфекций. Вирус кори попадает в окружающую среду при дыхании, кашле или чихании заболевшего человека. Один инфицированный корью человек может заразить 9 из 10 не вакцинированных лиц. Свою заразность во внешней среде вирус кори сохраняет до 2 часов, поэтому отсутствие прямого контакта с […]
21 февраля — День профилактики ИППП
В XIX веке врачи знали только две болезни, передающиеся половым путем: сифилис и гонорея. Их прозвали венерическими, по имени античной богини любви Венеры. На данный момент таких болезней гораздо больше. Вопросы изучения динамики заболеваемости и совершенствования мер профилактики инфекций, передаваемых половым путем (ИППП), являются весьма актуальными. Это обусловлено высоким общим уровнем распространения […]
Вейпы. И в чем их опасность?!
Электронные сигареты в последние годы набирают огромную популярность среди молодежи. Многие молодые люди начинают свой путь именно с электронных сигарет, думая, что это безопасно. Но это не так! Электронная сигарета, парогенератор, вапорайзер или вейп – это устройство, которое создаёт высокодисперсный аэрозоль, простыми словами пар, предназначенный для вдыхания. Пар генерируется […]
О новой универсальной вакцине «Конвасэл» против COVID-19
Вакцинация против COVID-19 остается важным шагом в укреплении здоровья, и новая универсальная вакцина «Конвасэл», производителем которой является Федеральное государственное унитарное предприятие «Санкт-Петербургский научно-исследовательский институт вакцин и сывороток и предприятие по производству бактерийных препаратов» Федерального медико-биологического агентства. Она представляет собой значимое достижение в борьбе с коронавирусом. Действие вакцины направлено на нуклеокапсидный N-белок вируса SARS-CoV-2, который является […]
16 января — День профилактики гриппа и ОРЗ
Зима — период сезонного подъема заболеваемости гриппом и острыми респираторными инфекциями (далее — ОРИ). Кажется что все вокруг кашляют и чихают. А самому болеть совсем не хочется. Как же предотвратить заболевание? И можно ли усилить иммунную защиту организма? Соблюдаем меры предосторожности Острые респираторные инфекции передаются преимущественно воздушно-капельным путем, то есть возбудители болезни попадают в организм с […]
Что нужно знать о птичьем гриппе
За последние три года случаи птичьего гриппа были зарегистрированы в 108 странах и территориях на пяти континентах, по данным Всемирной организации по охране здоровья животных. К декабрю 2024 года инфекция была обнаружена более чем у 70 видов домашних и диких млекопитающих. Грипп птиц – острое инфекционное заболевание, возбудителем которого является вирус. Основной естественный резервуар для большинства […]
Не омрачите праздничное настроение…
Государственное учреждение «Вороновский районный центр гигиены и эпидемиологии» в преддверии рождественских и новогодних праздников напоминает о мерах профилактики инфекционных заболеваний, острых кишечных инфекций, связанных с покупкой и употреблением пищевой продукции. Хочется в очередной раз напомнить жителям района о недопустимости приобретения пищевой продукции в несанкционированных местах торговли. Приобретая готовую пищевую продукцию в таких местах, вы подвергаете […]
Экскурсия по костелу святого Юрия в деревне Осова
15 декабря 2024 года коллектив Вороновского районного ЦГЭ в количестве 20 человек во главе с главным врачом Рекеть А.В. посетили костел святого Юрия в деревне Осова. Деревенька, где 9 жилых домов, стоит этот величественный храм из бутового камня 1909 года постройки. Священнослужитель храма Ян Петюн провел экскурсию по храму, рассказал про стариные иконы, фрески и […]
На что надо обратить внимание при выборе сладкого подарка ребенку к Новому году
Новый год – это праздник, который ждут дети и взрослые. В магазинах появляется большое количество сладких подарков в ярких упаковках. Родителей волнует вопрос, как выбрать не только красивый и оригинальный подарок для детей, но и безопасный и вкусный. Приобретая сладкий новогодний подарок, будьте предельно внимательны, изучайте информацию о товаре, указанную на этикетке! Покупайте новогодние сладкие […]
Эпидситуация по ВИЧ-инфекции
Каждый год в 1 день зимы во всем мире проводятся мероприятия в рамках Всемирной кампании против ВИЧ-инфекции, посвященные Всемирному дню борьбы со СПИДом. 1 декабря 2024 г. кампания проводится под лозунгом «Встать на путь отстаивания прав: мое здоровье – мое право!». В рамках кампании ВОЗ призывает мировых лидеров и граждан отстаивать право на здоровье и […]
Как уберечься от гололедных травм
Профилактика гололедных травм Гололед – это слой плотного льда, образовавшийся на поверхности земли, тротуарах, проезжей части улицы и на предметах (деревьях, проводах и т.д.) при намерзании переохлажденного дождя и мороси (тумана). Обычно гололед наблюдается при температуре воздуха от 0 0С до минус 3 0С. Корка намерзшего льда может достигать нескольких сантиметров. Если в прогнозе погоды дается […]
Как правильно выбрать хлеб…
Без хлеба невозможно насытиться даже самым питательным, богатым обедом с обилием различных блюд. И наоборот, если на столе присутствует это изделие из муки — считай, голодным не останешься. Хлеб испокон веков уважали и любили практически все народы, проживающие на планете Земля. На сегодняшний день, на прилавках наших магазинов можно увидеть десятки сортов хлеба, на любой […]
21 ноября — Всемирный день некурения. Профилактика онкологических заболеваний
Борьба с курением – необходимое условие улучшения здоровья населения. Табак содержит никотин – вещество, которое вызывает наркотическую зависимость и характеризуется навязчивой, непреодолимой тягой к его потреблению. Никотин – алкалоид, содержащийся в табаке (до 2%) и некоторых других растениях. Табачный дым вызывает и обостряет многие болезни, действуя практически на все органы. Значительное содержание в табаке […]
14 ноября – Всемирный день борьбы с диабетом
Диабет — это хроническое заболевание. Оно запускается, когда поджелудочная железа перестаёт вырабатывать достаточно инсулина или организм теряет способность эффективно использовать имеющийся. В нашем организме существует гормон инсулин, отвечающий за сохранение нормального уровня сахара в крови и обеспечивающий клетки энергией, тем самым формируя стабильную работу всего организма. Если вырабатывается недостаточно инсулина, уровень глюкозы зашкаливает, нарушается процесс […]
Всемирная неделя рационального использования антибиотиков пройдет с 11.11.2024 по 17.11.2024
Антибиотики (противомикробные средства) – это вещества синтетического или природного происхождения, которые уничтожают микроорганизмы (бактерицидное действие) или подавляют их способность к размножению (бактериостатическое действие). Термин антибиотик в переводе с греческого означает «против жизни». Действительно, этот тип препаратов уничтожает бактерии. Первый антибиотик, пенициллин, открытый в 1928 году, стал настоящим прорывом в медицине. Сегодня применение антибиотиков имеет как […]
Правильно выбираем стеклоомывающую жидкость
КАК ПРАВИЛЬНО ВЫБРАТЬ СТЕКЛООМЫВАЮЩУЮ ЖИДКОСТЬ С приближением холодной температуры для автомобилистов появляется проблема правильного выбора стеклоомывающей жидкости. Ведь на авторынке представлен достаточно широкий ассортимент данного товара. Владельцам автотранспорта рекомендуется очень внимательно отнестись к выбору стеклоомывающей жидкости. Она должна быть абсолютно безопасной как для водителя автомобиля, так и его пассажиров. Большинство зимних стеклоомывающих жидкостей изготавливают из […]
Витамины впрок…
Каждый из витаминов выполняет в организме свою особую функцию. Например, витамин А (аксерофтол, ретинол) отвечает за рост, состояние кожи и иммунитет человека. Витамин В1 регулирует работу мышц, центральной и периферической нервной системы, является составным элементом ферментов, регулирует обмен углеводов и аминокислот. Витамин В2 (рибофлавин) отвечает за рост и регенерацию клеток, регулирует обмен белков, жиров и […]
Как провести уборку в своем дворе?
КАК ПРОВЕСТИ УБОРКУ В СВОЁМ ДВОРЕ? Чистота и порядок во дворе дома не только способствуют созданию приятной атмосферы, но и являются залогом здоровья и безопасности его жителей. Уютный и ухоженный двор привлекает внимание, становится любимым местом отдыха для взрослых и игр для детей. В этой статье мы рассмотрим, как эффективно организовать уборку во дворе, чтобы […]
Об обследовании
Главным врачом Вороновского районного ЦГЭ Рекеть А.В., помощником врача-гигиениста санитарно-эпидемиологического отдела Вороновского районного ЦГЭ Зверко Е.В. совместно с начальником Радунского участка Астюшкевичем В.Э., начальником производственной лаборатории ОАО «Лидапищеконцентраты» Спагар Н.Н. проведена оценка соблюдения требований законодательства для предупреждения нарушений в области санитарно-эпидемиологического благополучия населения на Радунском участке ОАО «Лидапищеконцентраты». В ходе обследования проведено разъяснение практического применения […]
День отца
Согласно Указу Президента Республики Беларусь от 09.06.2022 №198 в Беларуси установлен новый праздник – День отца, который отмечается 21 октября. Поскольку в Беларуси сложилась многолетняя традиция отмечать 14 октября День матери, то теперь появилась возможность с 14 по 21 октября проводить родительскую неделю или Неделю семьи. В день отца поздравления принимают мужчины, которые взяли на […]
Специфика организации питания в школе, выполнение требований
16.10.2024 в ГУО «Заболотская средняя школа» проведено родительское собрание, где помощником врача-гигиениста ГУ «Вороновский районный центр гигиены и эпидемиологии» освещена тема «Специфика организации питания в школе, выполнение требований». «Здоровье дороже золота», — сказал английский поэт и драматург Уильям Шекспир. Наше здоровье – самое ценное, что у нас есть. Одним из главных условий нормального развития школьника […]
14 октября – День матери
Ежегодно 14 октября отмечается самый теплый и трогательный праздник – День матери. Своим приходом он напоминает, что в жизни каждого из нас самый главный человек – это мама. Мама – это целый мир, это безграничная любовь, это уют, добро и знания в одном лице! Именно мама дает начало новой жизни. С самого детства мы тянемся […]
Всемирный день психического здоровья
Всемирный день психического здоровья имеет свою дату 10 октября и отмечается в мире с 1992 года по инициативе Всемирной федерации психического здоровья, с целью повышения информированности населения в отношении проблем психического здоровья и способов его укрепления, а также профилактики и лечения психических расстройств. Психическое здоровье – это одно из фундаментальных прав каждого человека. Каждый, независимо […]
Всемирный день хосписной и паллиативной помощи
Всемирный день хосписной и паллиативной помощи (World Hospice and Palliative Care Day) отмечается во вторую субботу октября. В 2024 году эта дата приходится на 12 октября. Всемирный день хосписной и паллиативной помощи был учрежден в 2005 году. Организатором его проведения является Всемирный альянс хосписной паллиативной помощи (The Worldwide Hospice Palliative Care Alliance, WHPCA) – международная неправительственная организация со штаб-квартирой в […]
03.10.2024 Семинар
Специалистами государственного учреждения «Вороновский районный центр гигиены и эпидемиологии» в связи с наступлением эпидсезона острых респираторных инфекций, с целью снижения уровня заболеваемости, проводится информационно-образовательная работа с населением по мотивации к проведению вакцинации против гриппа и COVID-19. 03.10.2024 года проведен семинар с административным персоналом и работниками ремонтно-механической мастерской аг.Жирмуны КСУП «Экспериментальная база «Октябрь» на тему «Профилактика […]
1 октября – Международный День пожилого человека
Ежегодно 1 октября в Республике Беларусь отмечается День пожилых людей. Этот день – знак признательности и уважения к людям старшего поколения. В Беларуси за последние 10 лет численность граждан старше 65 лет возросла до 17% от общей численности населения и сегодня составляет около 1,6 млн. человек. В возрасте старше 90 лет в республике проживает более […]
Родительское собрание «Профилактика вирусных инфекций в учреждениях образования»
В ГУО «Детский сад № 2 г.п.Вороново» прошло родительское собрание, где присутствовали представители РОЧС, Радунского социально-педагогического центра, Вороновского районного ЦГЭ. Тема «Профилактика вирусных инфекций в учреждениях образования» в настоящее время актуальна. Ведь маленькие дети подвержены таким заболеваниям. ОРВИ — острые респираторные вирусные инфекции, которые передаются воздушно-капельным путем. К этой группе заболеваний относятся грипп, парагрипп, аденовирусная, риновирусная […]
29 сентября – всемирный день сердца
Всемирный день сердца, начиная с 2011 года, отмечается 29 сентября и проводится под девизом «Сердце для жизни». Здоровье сердечно-сосудистой системы касается каждого человека в мире. Наши сердца сталкиваются со многими угрозами: от наследственных заболеваний и привычек образа жизни, до социальных и экологических условий. Сердечно-сосудистые заболевания являются одной из ведущих причин смерти в мире. Основные факторы […]
Всемирный день борьбы против бешенства
Бешенство, по-прежнему, остается серьезной и неразрешенной проблемой в мире. По данным Всемирной организации здравоохранения случаи заболевания бешенством людей регистрируются более чем в 150 странах мира. Ежегодно это заболевание уносит жизни 55 тысяч человек, в основном в странах Азии и Африки. В особой группе риска находятся дети, поскольку они чаще контактируют с животными, нежели взрослые. Почти […]
Семинар-практикум с работниками учреждений образования
26.09.2024 на базе государственного учреждения образования «Погородненская средняя школа» работа школы молодого руководителя и резерва кадров на заместителей руководителей учреждений образования. Тема данного мероприятия: «Особенности составления учебного плана, списка педагогических работников, которым устанавливается оклад, надбавки и доплаты с учетом педагогической нагрузки, и расписание учебных занятий». Задачи мероприятия: актуализировать и углубить знания по вопросам соблюдения требований […]
Декада «Золотой возраст»
В ГУК «Вороновская районная библиотека» 25.09.2024 проведено открытие декады «Золотой возраст». Ветеранов труда, пенсионеров поздравили с наступающим праздником и началом декады «Золотой возраст» заместитель председателя Вороновского райисполкома Карпович А.А., начальник управления по труду, занятости и социальной защите Вороновского райисполкома Кушелевич Н.А., председатель Вороновского районного совета ветеранов Сазон Л.К. Людмила Константиновна также рассказала о планах проведения мероприятий […]
Чистота прилегающей территории
Важные составляющие привлекательного поселка, деревни, в целом района, магазинов, административных объектов, частных подворий – это не только выкрашенные фасады и вымытые окна, но и чистота прилегающей территории. Чистота населенного пункта (своевременный сбор и удаление мусора, подкос сорной растительности, своевременный ремонт элементов благоустройства, должное содержание улично-дорожной сети, озеленение и другое) – это лицо населенного пункта, отдельно […]
25 СЕНТЯБРЯ – ВСЕМИРНЫЙ ДЕНЬ ЛЕГКИХ
Дыхание – основа самой жизни и здоровья, важнейшая функция и потребность! Жизнь без воздуха невозможна – люди дышат для того, чтобы жить! Легкие – главный орган дыхательной системы человеческого организма, занимающий почти всю полость грудной клетки. Как и любые другие, болезни легких бывают острыми и хроническими и вызваны как внешними, так и внутренними факторами, их […]
17 сентября – День народного единства
17 сентября – эта дата дорога для нашего народа как день воссоединения Западной и Восточной Беларуси. В далеком 1939 году восстановилась историческая справедливость в отношении белорусского народа, разделенного в 1921 году против его воли по условиям Рижского мирного договора. Восстановленное единство позволило белорусам выстоять в тяжелые годы Великой Отечественной войны, поднять страну из разрухи в […]
10 сентября – всемирный день предотвращения самоубийств
Суицидальное поведение – поведение, проявляющееся в виде фантазий, мыслей или действий, направленных на самоповреждение или самоуничтожение. Самоубийство (суицид) – намеренное, осознанное и быстрое лишение себя жизни. Проблема самоубийств существовала во все времена и в последние годы она стала наиболее актуальна. Число суицидов в мире растет с каждым годом. Как правило, в ментальности наших людей заложена […]
Семинар для индивидуальных предпринимателей района
Осуществляя какую-либо покупку, мы хотим, чтоб она была качественной, безопасной для нашего здоровья и обладала необходимыми потребительскими свойствами. К сожалению, на прилавках наших магазинов встречаются некачественные товары, как продовольственной, так и непродовольственной группы. Так, на долю изъятой из обращения пищевой продукции приходится около 32% на объекты частной формы собственности, и этот процент продолжает увеличиваться. Такое […]
Правильное и безопасное питание – залог здоровья
Специалистами государственного учреждения «Вороновский районный центр гигиены и эпидемиологии» совместно с инженерами технологами государственного учреждения «Вороновский районный центр для обеспечения деятельности бюджетных организаций и государственных органов» 27 и 28 августа проведены обучающие семинары с принятием зачета по гигиеническому обучению для работников объектов питания учреждений общего среднего образования. Закончилось лето, а для детей начинаются трудовые будни. […]
Как выбрать школьный рюкзак
Главная покупка к новому учебному году — школьный рюкзак. Его нужно выбирать особенно тщательно, чтобы вмещал все необходимое, при этом был устойчив к разным погодным условиям. Расскажем, как правильно выбрать школьный рюкзак ребенку. Одной из причин формирования неправильной осанки является школьный портфель. Поэтому к его выбору стоит отнестись серьезно. В Республике Беларусь существуют санитарные нормы и правила «Требования к производству и […]
Школьная форма для ребенка
В Республике Беларусь с 1 сентября 2024/2025 учебного года вводится обязательная школьная форма, единство в школьной одежде. Школьная форма – важная часть процесса обучения детей. Она прививает дисциплину, помогает школьникам осознать, что они являются участниками определенного сообщества. Надевая форму, ученик становится более ответственным и серьезным. При выборе школьной формы необходимо обратить внимание на ткань. Выбирайте […]
КОМФОРТ И ПОРЯДОК В КАЖДОМ ДВОРЕ
В наведении чистоты и порядка постоянно нуждаются общественные места, придомовые территории. Многие люди убеждены, что за всё отвечает руководство поселка и работники ЖКХ, которые, по их мнению, и должны везде наводить порядок. Да, есть виды работ по благоустройству, где ответственность несут только работники ЖКХ, вот только достичь желаемого результата в наведении чистоты без помощи жителей […]
Комплексная гигиеническая оценка условий труда
В целях оценки комплексного воздействия на организм работающего факторов производственной среды, тяжести и напряженности трудового процесса, установления уровней профессионального риска работающих, определения сроков прохождения периодических медицинских осмотров, разработки плана оздоровительных мероприятий работодателем проводится комплексная гигиеническая оценка условий труда. Необходимость проведения комплексной гигиенической оценки условий труда регламентирована специфическими санитарно-эпидемиологическими требованиями к условиям труда работающих, утвержденными постановлением […]
О качестве воды озер
С наступлением пляжного сезона специалистами Вороновского районного центра гигиены и эпидемиологии (далее — Вороновский районный ЦГЭ) с июня по август продолжается проводиться оценка санитарного состояния и благоустройства зон отдыха, и еженедельный лабораторный контроль качества воды поверхностных водных объектов. По результатам лабораторных исследований с мая по текущий период 2024 года вода соответствует гигиеническому нормативу «Показатели безопасности […]
Внимание — арбузы!
Арбузы являются хорошей питательной средой для микроорганизмов, так как в основной массе своей они состоят из сахаров и влаги. Поэтому при загрязнении мякоти арбуза микроорганизмы очень хорошо развиваются в этой естественной питательной среде, что может явиться причиной пищевого отравления данным продуктом. Хранить арбузы необходимо в местах, защищенных от насекомых, грызунов, домашних животных. При транспортировке и […]
Профилактика сальмонеллеза
Профилактика сальмонеллеза Сальмонеллез ‑ острая инфекционная болезнь, вызываемая бактериями рода Salmonella (кроме брюшного тифа и паратифов), попадающими в организм человека с пищевыми продуктами животного происхождения. Название бактерии происходит от имени американского микробиолога Даниеля Сальмона, открывшего ее в 1885 году. Наиболее эпидемически значимыми источниками возбудителя в настоящее время являются куры, крупный рогатый скот и свиньи. Наибольшую опасность сальмонеллез […]
28 ИЮЛЯ – ВСЕМИРНЫЙ ДЕНЬ ПРОФИЛАКТИКИ ГЕПАТИТОВ
Решение учредить такой день было принято на сессии Всемирной ассамблеи здравоохранения в 2010 году. Гепатит является одним из самых распространенных и опасных инфекционных заболеваний, от которого ежегодно умирает более миллиона человек. Именно поэтому необходимо понимать его как серьезную проблему для здравоохранения. Гепатит – это тяжелое инфекционное заболевание, характеризующееся явлениями общей интоксикации, преимущественным поражением печени, нарушением […]
Профилактика вирусного гепатита А
Вирусный гепатит А – острое инфекционное заболевание, протекающее с поражением печени. Согласно статистике ВОЗ, ежегодно в мире гепатитом А заболевает более полутора миллионов человек. Вирус гепатита А обладает высокой устойчивостью во внешней среде: сохраняется в течение нескольких месяцев при температуре +4°С, нескольких недель при комнатной температуре, несколько лет при температуре -20°С. При кипячении возбудитель погибает […]
Профилактика бруцеллеза
Бруцеллёз — зоонозное заболевание, передающееся от больных животных человеку. Данное заболевание характеризуюется длительным течением, поражением нервной и сердечно-сосудистой систем, а также костно-суставного аппарата. инфекционно-аллергическое заболевание, Источниками бруцеллезной инфекции для людей являются мелкий и крупный рогатый скот, а также свиньи, лошади, верблюды, собаки, кошки. Инкубационный период заболевания (время от контакта с больным животным до появления клинических симптомов) […]
О безопасности использования водных объектов для купания
Вороновский районный центр гигиены и эпидемиологии НАПОМИНАЕТ, что с наступлением пляжного сезона специалистами с июня по август проводится оценка санитарного состояния и благоустройства зон отдыха, и еженедельный лабораторный контроль качества воды поверхностных водных объектов. В соответствии с решением Вороновского районного исполнительного комитета «О мерах по предупреждению гибели людей на водах и подготовке к купальному сезону […]
Ботулизм
Ботулизм — острое инфекционное заболевание, характеризующееся парезами и параличами мышц в результате блокады передачи нервных импульсов токсинами возбудителя болезни Clostridium botulinum. Пищевой ботулизм развивается в результате употребления пищевых продуктов, в которых произошло накопление ботулинического нейротоксина и возбудителя. Возбудитель ботулизма – Clostridium botulinum. Бактерия существует в двух формах: вегетативная — состояние роста, размножения и активной продукции токсина; в виде […]
11 ИЮЛЯ – ДЕНЬ ПРОФИЛАКТИКИ АЛКОГОЛИЗМА
Похититель рассудка – так именуют алкоголь с давних времен. История алкоголя – это история всего человечества. О точной дате начала производства алкоголя нам не скажут древние трактаты, потому что письменности в то время не было. Но археологические находки и лабораторные исследования остатков древних сосудов позволяют утверждать о широком виноделии ещё в эпоху неолита. В найденных […]
Листериоз
Листериоз – инфекционное заболевание человека и животных, характеризующееся множеством источников инфекции, разнообразием путей и факторов передачи, а также клинических проявлений. Листериоз распространен во всех странах мира, регистрируется среди всех возрастных групп и в любое время года. Инфекция представляет особую опасность для беременных, новорождённых, людей старше 65 лет, лиц с ослабленным иммунитетом. Резервуаром и источником листериоза […]
Правила безопасного поведения в жару
Ввиду предстоящей жаркой погоды государственное учреждение «Вороновский районный центр гигиены и эпидемиологии» напоминает о необходимости соблюдения правил безопасности в жару с целью профилактики теплового и солнечного ударов. Всем без исключения рекомендуется соблюдать следующие правила: сократить время пребывания на улице во время наибольшей солнечной активности с 11.00 до 16.00, отдавая предпочтение утренним и вечерним часам; отказаться от занятий физическими упражнениями […]
Методы профилактики инфекционных заболеваний
Методы профилактики инфекционных заболеваний Инфекционные заболевания включают группу недугов, возникающих из-за бактерий, вирусов, паразитов и других микроорганизмов. Защититься от них поможет эффективная профилактика: вакцинация, гигиена, здоровый образ жизни. Профилактика инфекционных заболеваний требуется каждому человеку. Из-за ослабленного иммунитета организм подвергается разным недугам, и тогда вирусы, бактерии и прочие микроорганизмы активно развиваются и мутируют. Стремительное развитие вирусов […]
06 июня 2024 года специалистами Вороновского районного ЦГЭ проведено обучающее занятие с работниками Радунского лесничества ГЛХУ Лидский лесхоз на тему: «Клещевые инфекции. Меры профилактики. Профилактика бешенства. Основные аспекты инфекционной и неинфекционной заболеваемости«
О качестве воды зон рекреации
С наступлением пляжного сезона специалистами Вороновского районного центра гигиены и эпидемиологии (далее — Вороновский районный ЦГЭ) с июня по август проводится оценка санитарного состояния и благоустройства зон отдыха, и еженедельный лабораторный контроль качества воды поверхностных водных объектов. В соответствии с решением Вороновского районного исполнительного комитета «О мерах по предупреждению гибели людей на водах и подготовке […]
Вместе за чистоту
Наведение порядка и благоустройство территории — дело всех жителей. Каждый гражданин должен помнить, что он обязан поддерживать чистоту и порядок, содержать в надлежащем состоянии территорию, не допускать сжигания отходов, сухой растительности, не производить мойку автотранспорта на улицах, у водоразборных колонок и колодцев, в водоемах и других местах общего пользования, соблюдать требования в области охраны окружающей […]
Здоровый образ жизни — наша жизнь
Здоровый образ жизни – это как огнетушитель, все знают, как он необходим, но вспоминают только в случае крайней необходимости. В настоящее время ЗОЖ в моде, и следование принципам здорового образа жизни, предмет гордости волевых и целеустремленных людей. 27.05.2024 на базе Вороновского районного ЦГЭ проведен «круглый стол» на тему «Здоровый образ жизни – наша жизнь» для […]
Безопасное лето для детей
В Вороновском районе согласно решения Вороновского районного исполнительного комитета от 07.05.2024 № 305 «Об организации оздоровления детей Вороновского района в летний период 2024 года» готовятся к открытию 26 оздоровительных лагерей с дневным пребыванием на базе учреждений образования и 15 лагерей с круглосуточным пребыванием, из них 4 палаточных лагеря, расположенных в лесной (лесопарковой) зоне, 1 стационарный […]
Единый день информирования
16 мая 2024 года в Вороновском районном ЦГЭ прошел единый день информирования. На встрече обсуждались: Ключевые аспекты Послания Президента Республики Беларусь Александра Лукашенко к белорусскому народу и Национальному собранию. Профилактика преступлений, связанных с неправомерным завладением реквизитами пластиковых банковских карт и хищением средств с карт-счетов граждан, а также в сфере высоких технологий. Обеспечение безопасности детей при […]
Тренировочное учение
16 мая 2024 года в международном автомобильном пункте пропуска «Бенякони» проведено тренировочное учение по обеспечению санитарной охраны от завоса и распространения инфекционных заболеваний, имеющих международное значение. В учениях принимали участие специалисты Вороновского районного ЦГЭ, Лидского зонального ЦГЭ, отделение скорой медицинской помощи УЗ «Вороновская ЦРБ», пограничной службы, Гродненской региональной таможни.
Обучающий семинар-практикум
В государственном учреждении «Вороновский районный центр гигиены и эпидемиологии» 24.04.2024 организован и проведен обучающий семинар-практикум для работников организаций (предприятий), ответственных за отбор проб воды питьевой, пищевых продуктов, смывов и доставку в лабораторию в рамках выполнения программы производственного лабораторного контроля разработанной субъектами хозяйствования. В ходе проведения семинара обращено внимание специалистов, ответственных за водоснабжение в организациях района, […]
Штаб по наведению порядка
9 апреля 2024 года в Вороновском районе прошло заседание штаба по наведению порядка на земле и благоустройству населенных пунктов. На заседании штаба выступил главный врач Вороновского районного ЦГЭ Рекеть Александра Владиславовна. «Недопустимо складирование крупногабаритных и строительных отходов на улицах и территориях общественного пользования», — заострила внимание присутствующих главный санитарный врач района Александра Рекеть. Подробнее
Бешенство
Бешенство — инфекционное заболевание, которое развивается в результате заражения вирусом Rabiesvirus. Болезнь характеризуется стремительным и тяжелым течением, а также высокой вероятностью летального исхода. Вирус проникает в организм человека после укуса зараженным животным. Пути заражения Возбудитель бешенства содержится в слюне зараженных животных, иногда обнаруживается в слезной жидкости и моче. Он распространен преимущественно среди бездомных и диких […]
Районные учения
17 апреля 2024 в УЗ «Вороновская ЦРБ» совместно с ГУ «Вороновский районный ЦГЭ» прошли районные учения. На учениях отработали действия медицинских работников и специалистов ЦГЭ при выявлении больного холерой. По легенде, женщина прибывшая из страны, неблагополучной по холере, обратилась в приемный покой Вороновской ЦРБ. Все клинические признаки указывали на холеру. Участники быстро и четко отработали […]
Вирусный гепатит А
Гепатит А — болезнь печени, вызываемая вирусом гепатита А. Вирус гепатита А поражает печень, вызывая гибель её клеток. Заболевание начинается с недомогания, тошноты и рвоты, повышения температуры, болей и тяжести в правом подреберье, снижения аппетита. Позднее кожа и слизистые покровы окрашиваются в желтый цвет (народное название болезни – «желтуха»), изменяется цвет кала (обесцвечивается) и мочи (приобретает […]
Корь
Что такое корь? Корь — это высокозаразная вирусная болезнь, которая передается воздушно-капельным путем. Источник инфекции — человек больной корью в любой форме, который заразен для окружающих с последних дней инкубационного периода (последние 2 дня) до 4-го дня высыпаний. С 5-го дня высыпаний больной считается незаразным. Вирус кори обладает высокой летучестью — с потоками воздуха по вентиляционным трубам […]
О состоянии питьевого водоснабжения
Специалистами государственного учреждения «Вороновский районный центр гигиены и эпидемиологии» осуществляется постоянный контроль качества и безопасности подаваемой питьевой воды в соответствии с планом социально-гигиенического мониторинга путем проведения ежемесячных лабораторных исследований. За 1 квартал 2024 года из контрольных точек систем питьевого водоснабжения по всей территории Вороновского района отобрано 80 проб воды на санитарно-химические и микробиологические показатели. Удельный вес нестандартных […]
Оценка соблюдения санитарно-эпидемиологических требований в сельскохозяйственных организациях
Для сельскохозяйственных предприятиях района настала очень напряженная пора – время весенних полевых работ. Чтобы данная работа проходила без осложнений и внештатных ситуаций, 03.04.2024 года помощником врача-гигиениста санитарно-эпидемиологического отдела Вороновского районного ЦГЭ Зверко Е.В. совместно с председателем Вороновского районного объединения профсоюзов Жемайтук В.З. проведена оценка соблюдения санитарно-эпидемиологических требований в сельскохозяйственных организациях. Цель данного мероприятия – профилактика […]
Правила выбора качественных продуктов
Внимательно изучите название. В большинстве случаев стандартное название продукта — синоним качества, соответствующего государственному стандарту. То есть только «Сметана», и никакой «Сметанки» или «Сметановны», только «Сгущенное молоко», а не «Продукт молочный с сахаром», «Кефир», а не «Кефирный продукт» и т.д. Выбирайте те продукты, на которых указано соответствие ГОСТу. ГОСТ — это совокупность требований к качеству продукта, установленных […]
Полезные свойста березового сока
Наступила весна и совсем скоро начнется сезон сбора березового сока. Этот напиток часто ассоциируется с первыми весенними теплыми солнечными днями, первыми подснежниками и запахом леса. Вековая традиция сбора березового сока и его употребления в пищу связана с его несомненными полезными свойствами. Одним из главных полезных качеств березового сока является высокое содержание витаминов и минералов, которые […]
Неделя нулевого травматизма
В рамках областного Дня охраны труда проводится «Неделя нулевого травматизма» с единой повесткой «Электробезопасность. Требования по охране труда при работе с переносным электроинструментом. Обеспечение электротехнического персонала средствами защиты». Основные требования безопасности при работе с ручным электромеханическим инструментом заключаются в следующем: Перед началом работ с электроинструментом работающему следует внешним осмотром убедиться в том, что: кабель (провод) и […]
Семинар
В государственном учреждении «Вороновский районный центр гигиены и эпидемиологии» 06.03.2024 проведен ежегодный семинар «Основы законодательства в области санитарно-эпидемиологического благополучия населения при приготовлении, транспортировке и раздаче пищи лицам, занятым на массовых сельскохозяйственных работах. Основные аспекты профилактики инфекционной и не инфекционной заболеваемости» с работниками сельскохозяйственных организаций, занятые приготовлением, транспортировкой и раздачей горячих обедов, на массовых сельхозработах. В […]
Семинар с инженерами по охране труда
06 марта 2024 года в государственном учреждении «Вороновский центр гигиены и эпидемиологии» прошел семинар с инженерами по охране труда сельскохозяйственных организаций. Основная тема семинара «Санитарно-эпидемиологические требования к условиям труда работающих, содержанию и эксплуатации производственных объектов». Озвучивались и обсуждались общие вопросы к условиям труда работающих, требования к содержанию и эксплуатации санитарно-бытовых помещений, санитарно-бытовому обеспечению работающих, организации […]
Профориентационная работа
Перед каждым поколением школьников рано или поздно встает проблема выбора дальнейшего пути. От правильного самоопределения зависит успех всей жизни человека, так как работа является основной деятельностью во взрослой жизни. То, чем человек будет заниматься в будущем, будет существенно влиять на его финансовое положение, социальный статус, общество, с которым придется пересекаться и общаться, т.е. на всю […]
Меры безопасности при работе пестицидами (средствами защиты растений), агрохимикатами и минеральными удобрениями
Начинается сезон массовых полевых работ, в ходе которого не возможно обойтись без применения ядохимикатов. Особую опасность для населения представляют пестициды — химические вещества, бактериологические препараты и продукты микробиологического синтеза, используемые и сельском хозяйстве для борьбы с вредителями и болезнями культурных растений, сорной растительностью, вредителями зерна и пищевых продуктов. Они, как правило, являются ядами для человека […]
Вирусный гепатит А (ВГА)
Гепатит А — это воспалительное заболевание печени, вызываемое вирусом гепатита А (ВГА). Вирус распространяется главным образом в результате употребления неинфицированным (и невакцинированным) лицом пищевых продуктов или воды, загрязненных фекалиями инфицированного человека. Это заболевание тесно связано с некачественным водоснабжением или заражением продуктов питания, плохими санитарными условиями, несоблюдением правил личной гигиены. В отличие от гепатитов B и C, […]
ПРОФИЛАКТИКА ИНФЕКЦИЙ, ПЕРЕДАЮЩИХСЯ ПОЛОВЫМ ПУТЁМ
Заразиться ИППП может любой человек, вне зависимости от возраста и пола. Заражение происходит в основном в результате сексуальных контактов от человека человеку, некоторыми инфекциями можно заразиться при пользовании общими мочалкой, полотенцем. ИППП не передаются при рукопожатии, чихании, дружеском поцелуе, укусах насекомых, от животных, при купании, при пользовании столовыми принадлежностями. Многие из группы этих инфекций протекают […]
Корь
Эпидемиологическая ситуация по заболеваемостью корью в Республике Беларусь ухудшилась, в 2023 году зарегистрировано более 140 случаев кори. В ноябре отмечен выраженный подъем заболеваемости, зарегистрировано более 90 случаев. Случаи заболевания регистрируются преимущественно на территории Брестской, Гомельской, Минской областей и г. Минске. В Гродненской области за 11 месяцев текущего года зарегистрировано 2 случая заболевания (г.Слоним и г.Гродно). В […]
О проведении акции
Для населения Вороновского района в период с 22.01.2024 по 31.01.2024 года проводится информационная акция «Респираторный этикет говорит инфекциям «Нет!». Целью данной акции является ограничение распространения острых респираторных инфекций и гриппа. В рамках проведения акции 22.01.2024 в ГУО «Беняконская средняя школа» специалистами Вороновского районного центра гигиены и эпидемиологии проведен «круглый стол» для учащихся 1-4 и 5-6 классов на […]
21 января — день профилактики гриппа и ОРИ
Зима — период сезонного подъема заболеваемости гриппом и острыми респираторными инфекциями (далее — ОРИ). Кажется что все вокруг кашляют и чихают. А самому болеть совсем не хочется. Как же предотвратить заболевание? И можно ли усилить иммунную защиту организма? Соблюдаем меры предосторожности Острые респираторные инфекции передаются преимущественно воздушно-капельным путем, то есть возбудители болезни попадают в организм с […]
Овощи на нашем столе
Простой способ сделать праздничный стол здоровым и легким — это добавить в меню побольше овощей, в том числе салаты. Однако важно помнить о правилах обработки и приготовления овощей, что позволит сохранить в них максимальное количество полезных веществ. Овощи играют важную роль в питании человека. С ними в наш организм поступает довольно большая часть углеводов, они […]
Правильное питание ребенка – залог здоровья
Каждый родитель хочет, чтобы его ребенок рос здоровым, умным, счастливым. С самого детства мы должны научить своих детей из всего многообразия продуктов выбирать те, которые действительно полезны для здоровья. Питание детей несколько отличается от питания взрослых. Если система питания ребёнка выстроена правильно, то ребёнок, нормально развивается, как физически, так и психически. Сделайте так, чтобы ежедневное приобщение […]